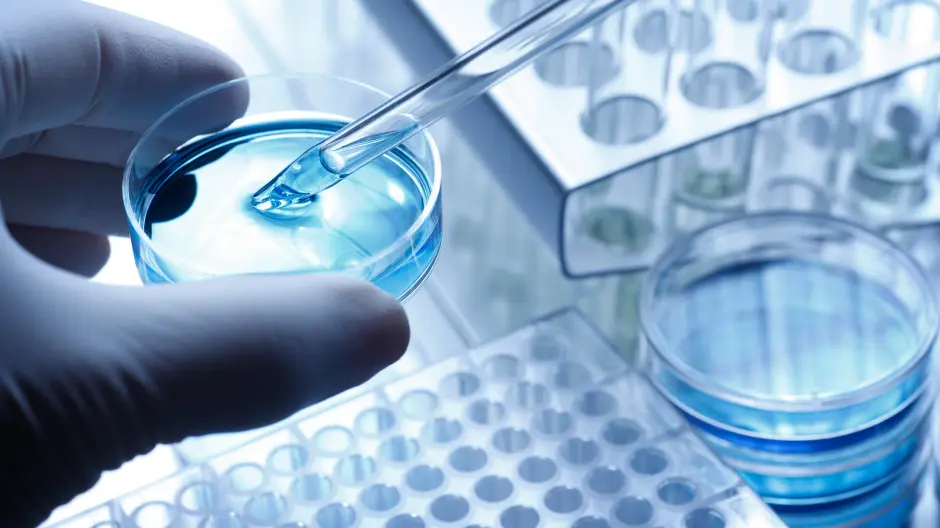

Research Area Introduction
![]() |
Every year there are about four million new cases of cancer diagnosed in the world, with over eight million cancer-related deaths. There are over 100 different types of cancer, with often significant genotypic and phenotypic heterogeneity even among tumors of the same kind. Research is one of the best weapons to oppose this scourge, and great progress has been made in cancer diagnosis, treatment, and prevention. In addition, scientists have made enormous strides dissecting the mechanisms and pathways that drive carcinogenesis and metastasis, and in offering approaches as to how these processes can be potentially targeted for therapeutic purposes.